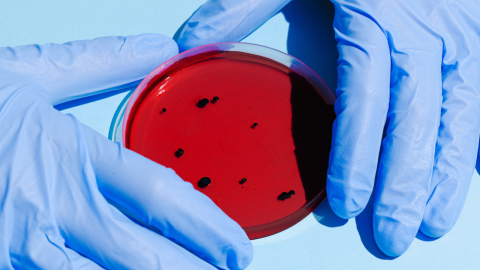
muerte celular proceso detener

Un grupo de investigadores descubrió que es posible detener el proceso de muerte celular programada conocido como la piroptosis, causada usualmente por una infección que resulta en un exceso de inflamación en el cuerpo, y que durante mucho tiempo se creía que era irreversible.
Se trata de un estudio publicado por investigadores de la Universidad de Illinois en Chicago describe un nuevo método para analizar la piroptosis y muestra que el proceso, que durante mucho tiempo se pensó que era irreversible una vez iniciado, de hecho se puede detener y controlarlo.
Este descubrimiento, que se informa en la prestigiosa revista científica Nature, significa que los científicos tienen una nueva forma de estudiar las enfermedades relacionadas con el mal funcionamiento de los procesos de muerte celular.
Ejemplo de estas enfermedades relacionadas con la muerte celular son algunos tipos de cáncer e infecciones empeoradas por la inflamación descontrolada como la sepsis y el síndrome de dificultad respiratoria aguda, una de las principales complicaciones presentes en la Covid-19.
Piroptosis: proceso de muerte celular que ahora se puede detener y controlar
Para comprender más acerca del proceso de la piroptosis, los investigadores de la UIC diseñaron una gasdermina "optogenética" modificando genéticamente la proteína para que responda a la luz.
"El proceso de muerte celular juega un papel importante en el cuerpo, tanto en estados saludables como no saludables, pero estudiar la piroptosis, que es un tipo importante de muerte celular, ha sido un desafío”, señaló Gary Mo asistente de la UIC en el departamento de farmacología y medicina regenerativa.
Los investigadores utilizaron tecnología de imágenes fluorescentes para activar con precisión la gasdermina en experimentos con células y observar los poros en diversas circunstancias.
Descubrieron que ciertas condiciones, como concentraciones específicas de iones de calcio, por ejemplo, provocaron que los poros se cerraran en solo decenas de segundos. Esta respuesta automática a las circunstancias externas proporciona evidencia de que la piroptosis se autorregula dinámicamente.

"Esto nos mostró que esta forma de muerte celular no es un billete de ida. El proceso en realidad está programado con un botón de detener, un interruptor de apagado (...) comprender cómo controlar este proceso abre nuevas vías para el descubrimiento de fármacos”, concluyó Gary Mo.
La noticia por todos los medios. ¡Descarga nuestra app !
ME







